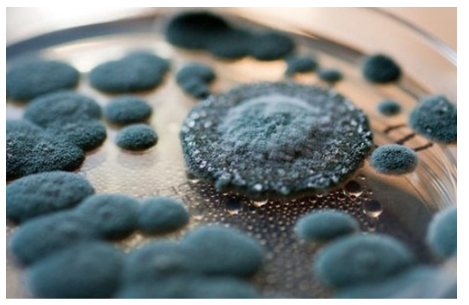
Mẫn cảm là hệ miễn dịch của cơ thể được kích thích để tạo ra kháng thể chống lại tác nhân gây bệnh

1. Mẫn cảm là gì?
Khi các tác nhân gây bệnh xâm nhập vào cơ thể, hệ thống miễn dịch sẽ được kích thích để tạo ra kháng thể chống lại tác nhân gây bệnh, đó chính là biện pháp bảo vệ đặc hiệu của cơ thể, gọi là mẫn cảm. Tùy vào cơ chế bệnh sinh và vị trí tác nhân gây bệnh, hệ miễn dịch sẽ có phương pháp mẫn cảm phù hợp.
2. Các phương pháp mẫn cảm 
Cơ chế miễn dịch đặc hiệu của cơ thể được hình thành bởi mẫn cảm chủ động hoặc mẫn cảm thụ động. Cả hai loại hình mẫn cảm này đều xảy ra một cách tự nhiên hoặc nhân tạo.
2.1 Mẫn cảm thụ động
Mẫn cảm thụ động là miễn dịch của cơ thể có được nhưng không cần phải tiếp xúc với kháng nguyên.
Miễn dịch thụ động có được bằng cách truyền Huyết thanh (hoặc gamma globulin) từ người có miễn dịch sang người không có miễn dịch. Hoặc sử dụng cá thể được mẫn cảm để tạo ra tế bào miễn dịch và truyền tế bào đó cho người không có miễn dịch.
- Miễn dịch thụ động tự nhiên: Là miễn dịch được truyền từ mẹ cho thai nhi thông qua nhau thai (IgG) hoặc qua sữa non (IgA).
- Miễn dịch thụ động nhân tạo: Là truyền kháng thể của người hoặc động vật đã miễn dịch cho người chưa có miễn dịch. Biện pháp mẫn cảm này thường được áp dụng trong các tình huống điều trị dự phòng cấp tính một số bệnh như sởi, uốn ván, bạch hầu, dại, hoặc Ngộ độc do côn trùng, thực phẩm thịt, .. Cả kháng thể từ người và động vật đều mang lại hiệu quả và giúp cung cấp miễn dịch tức thì, tuy nhiên kháng thể khác loài thường gây Sốc phản vệ và biến chứng bệnh lý, thời gian hiệu quả ngắn. Trong khi đó, kháng thể đồng loài có nguy cơ lây truyền các bệnh như HIV, viêm gan, ....
2.2 Mẫn cảm chủ động
Mẫn cảm chủ động là miễn dịch của cơ thể được hình thành sau khi tiếp xúc với kháng nguyên.
- Miễn dịch chủ động tự nhiên: Là cơ thể tạo ra kháng thể đáp ứng miễn dịch để bảo vệ và chống lại tác nhân gây bệnh sau khi tiếp xúc với tác nhân gây bệnh làm nhiễm trùng nhưng chưa xuất hiện triệu chứng, hoặc xuất hiện triệu chứng lâm sàng.
- Miễn dịch chủ động nhân tạo: Là cơ thể tạo ra kháng thể đáp ứng miễn dịch để bảo vệ và chống lại tác nhân gây bệnh sau khi tiếp xúc với tác nhân gây bệnh đã chết, hoặc còn sống hoặc các thành phần của tác nhân. Biện pháp mẫn cảm chủ động này chính là tiêm vắc-xin bao gồm vắc-xin sống giảm độc lực, vắc-xin bất hoạt, vắc-xin tiểu đơn vị và vắc-xin giải độc tố. Tiêm vắc-xin có thể tạo ra miễn dịch bảo vệ suốt đời đối với một số bệnh như lao, sởi, quai bị, rubella, thủy đậu,... hoặc cũng có thể kéo dài trong vài tháng. Ngoài ra, một biện pháp làm tăng đáp ứng miễn dịch khác là tiêm các kháng nguyên đã được làm yếu hơn bằng cách cho thêm tá dược, là những chất hóa học và sinh học.
3. Các loại vắc-xin được dùng để gây mẫn cảm chủ động nhân tạo 
3.1 Vắc-xin sống giảm độc lực
Vắc-xin sống giảm độc lực chứa những vi khuẩn, virus, tác nhân gây bệnh còn sống nhưng đã được làm giảm độc lực để tạo khả năng miễn dịch, bao gồm miễn dịch dịch thể và miễn dịch qua trung gian tế bào.
Tuy nhiên, biện pháp mẫn cảm bằng cách dùng vắc-xin sống giảm độc lực có thể làm tăng nguy cơ gây bệnh đối với người bị suy giảm miễn dịch.
Vắc-xin sống giảm độc lực phòng ngừa các bệnh Nhiễm trùng do virus như lao, sởi, thủy đậu, quai bị, rubella, viêm gan A, Sốt vàng da, ...
3.2 Vắc-xin bất hoạt
Vắc-xin bất hoạt chứa virus chết, được bất hoạt bằng nhiệt, hóa chất hoặc tia cực tím. Vắc-xin bất hoạt phòng ngừa các bệnh như bại liệt, cúm, dại, tả, thương hàn, Ho gà, dịch hạch, ....
3.3 Vắc-xin giải độc tố
Vắc-xin tiểu đơn vị chứa virus đã được làm giảm độc tính của chất độc do virus sinh ra và kháng nguyên cần thiết để sinh ra miễn dịch. Biện pháp mẫn cảm này mang lại hiệu lực kém hơn so với vắc-xin sống giảm độc lực. Vắc-xin tiểu đơn vị phòng ngừa các bệnh như bạch hầu, uốn ván, ...
4. Tác dụng của mẫn cảm chủ động nhân tạo 
Phần lớn biện pháp mẫn cảm chủ động nhân tạo được dùng để dự phòng, tức là tiêm vắc-xin để phòng ngừa tác nhân gây bệnh. Tuy nhiên, trong một số trường hợp như bệnh dại, có thể dùng vắc-xin để điều trị sau khi cơ thể bị tấn công bởi virus gây bệnh. Tùy vào các điều kiện sau, biện pháp gây mẫn cảm này sẽ có hiệu quả khác nhau:
- Cơ chế gây bệnh
- Thời gian ủ bệnh
- Tốc độ sao chép của tác nhân gây bệnh






